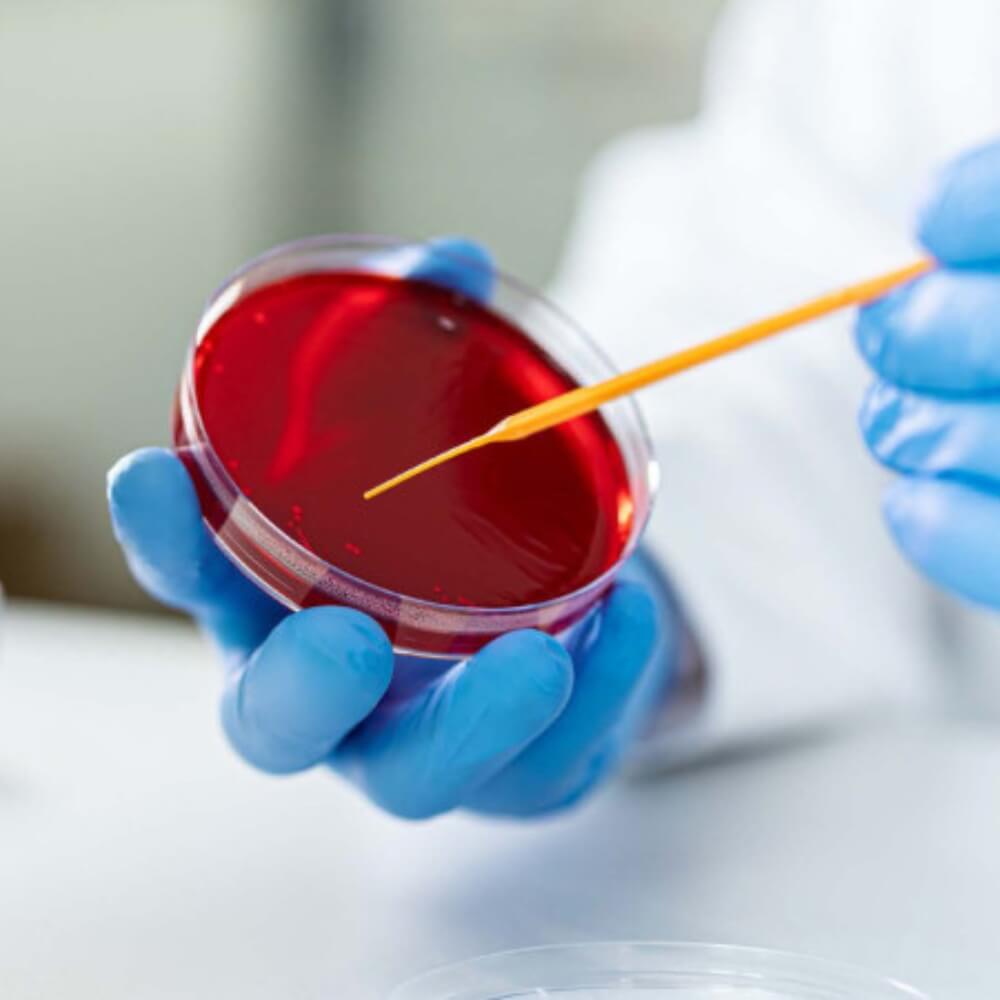

| Fragt | |||
| Total Moms |
|
||
| Total inkl. moms |


Pipetter og pipettespidser med nøjagtige doseringer danner grundlag for præcise og pålidelige eksperimenter. Kompatibiliteten mellem pipetterne og pipettespidserne er et særligt vigtigt aspekt, der påvirker nøjagtigheden og pålideligheden af resultaterne.
SARSTEDT producerer både den ergonomiske Sarpette® M pipette og udvejede pipettespidser, der giver præcis og effektiv pipettering.


Den rigtige prøvebeholder er et afgørende element i enhver analyse. Som en af verdens førende producenter af rør og beholdere til laboratorier tilbyder SARSTEDT en bred vifte af prøvebeholdere af høj kvalitet, der optimerer og forenkler dit arbejde.
Kvaliteten af prøvebeholderne har en væsentlig indflydelse på pålideligheden og nøjagtigheden af dine resultater. Prøvebeholdere fra SARSTEDT er kendetegnet ved stor alsidighed og kompatibilitet med almindeligt laboratorieudstyr. De er lækagesikre og bidrager til sikker transport og opbevaring af dine prøver.


Molekylærbiologi undersøger funktionen af DNA, RNA og proteinbiosyntese og bidrager til identifikation af fysiologiske og patofysiologiske processer.
Renrumsforhold, uddannet personale og automatiserede produktionsprocesser er de grundlæggende forudsætninger for SARSTEDTs certificerede kvalitetsstandarder: 'PCR Performance Tested' og 'Biosphere® plus'. Produkterne gennemgår omfattende kvalitetstjek under hele fremstillingsprocessen for at sikre pålidelige og yderst reproducerbare resultater.


Studiet af cellekulturer er uundværlig i grund- og lægemiddelforskning. SARSTEDTs omfattende produktlinje består af celledyrkningsflasker, -skåle og -plader samt ekstra tilbehør, der er skræddersyet til at opfylde behovene for de fleste celletyper. SARSTEDT celledyrkningsprodukter findes med tre forskellige vækstoverflader til en bred vifte af in vitro-forhold.

Indenfor mikrobiologi og bakteriologi er sterilitet af afgørende betydning, og kontaminering skal undgås for at sikre pålidelige resultater. SARSTEDT tilbyder her en række forbrugsartikler, der har gennemgået streng kvalitetskontrol for at sikre deres renhed og sporbarhed.
SARSTEDTs brede portefølje af produkter til indsamling, forberedelse og analyse af mikrobiologiske prøver er omhyggeligt udviklet for at optimere arbejdsgange og muliggøre nøjagtige, reproducerbare resultater. Produkterne opfylder de højeste standarder for sterilitet, kvalitet og kompatibilitet.


Med over 60 års erfaring som familieejet virksomhed har SARSTEDT fokus på hele værdikæden. Virksomhedens tilgang til miljøet er styret af FN's 17 Verdensmål, hvor fokus særligt er på sundhed, uddannelse, klimabeskyttelse og bæredygtig produktion.
SARSTEDT arbejder vedvarende med effektive processer, minimalt ressourceforbrug og innovative løsninger med lavt spild. Virksomheden lægger vægt på meningsfuldt genbrug for at fremme ansvarlig forvaltning af naturressourcerne.







